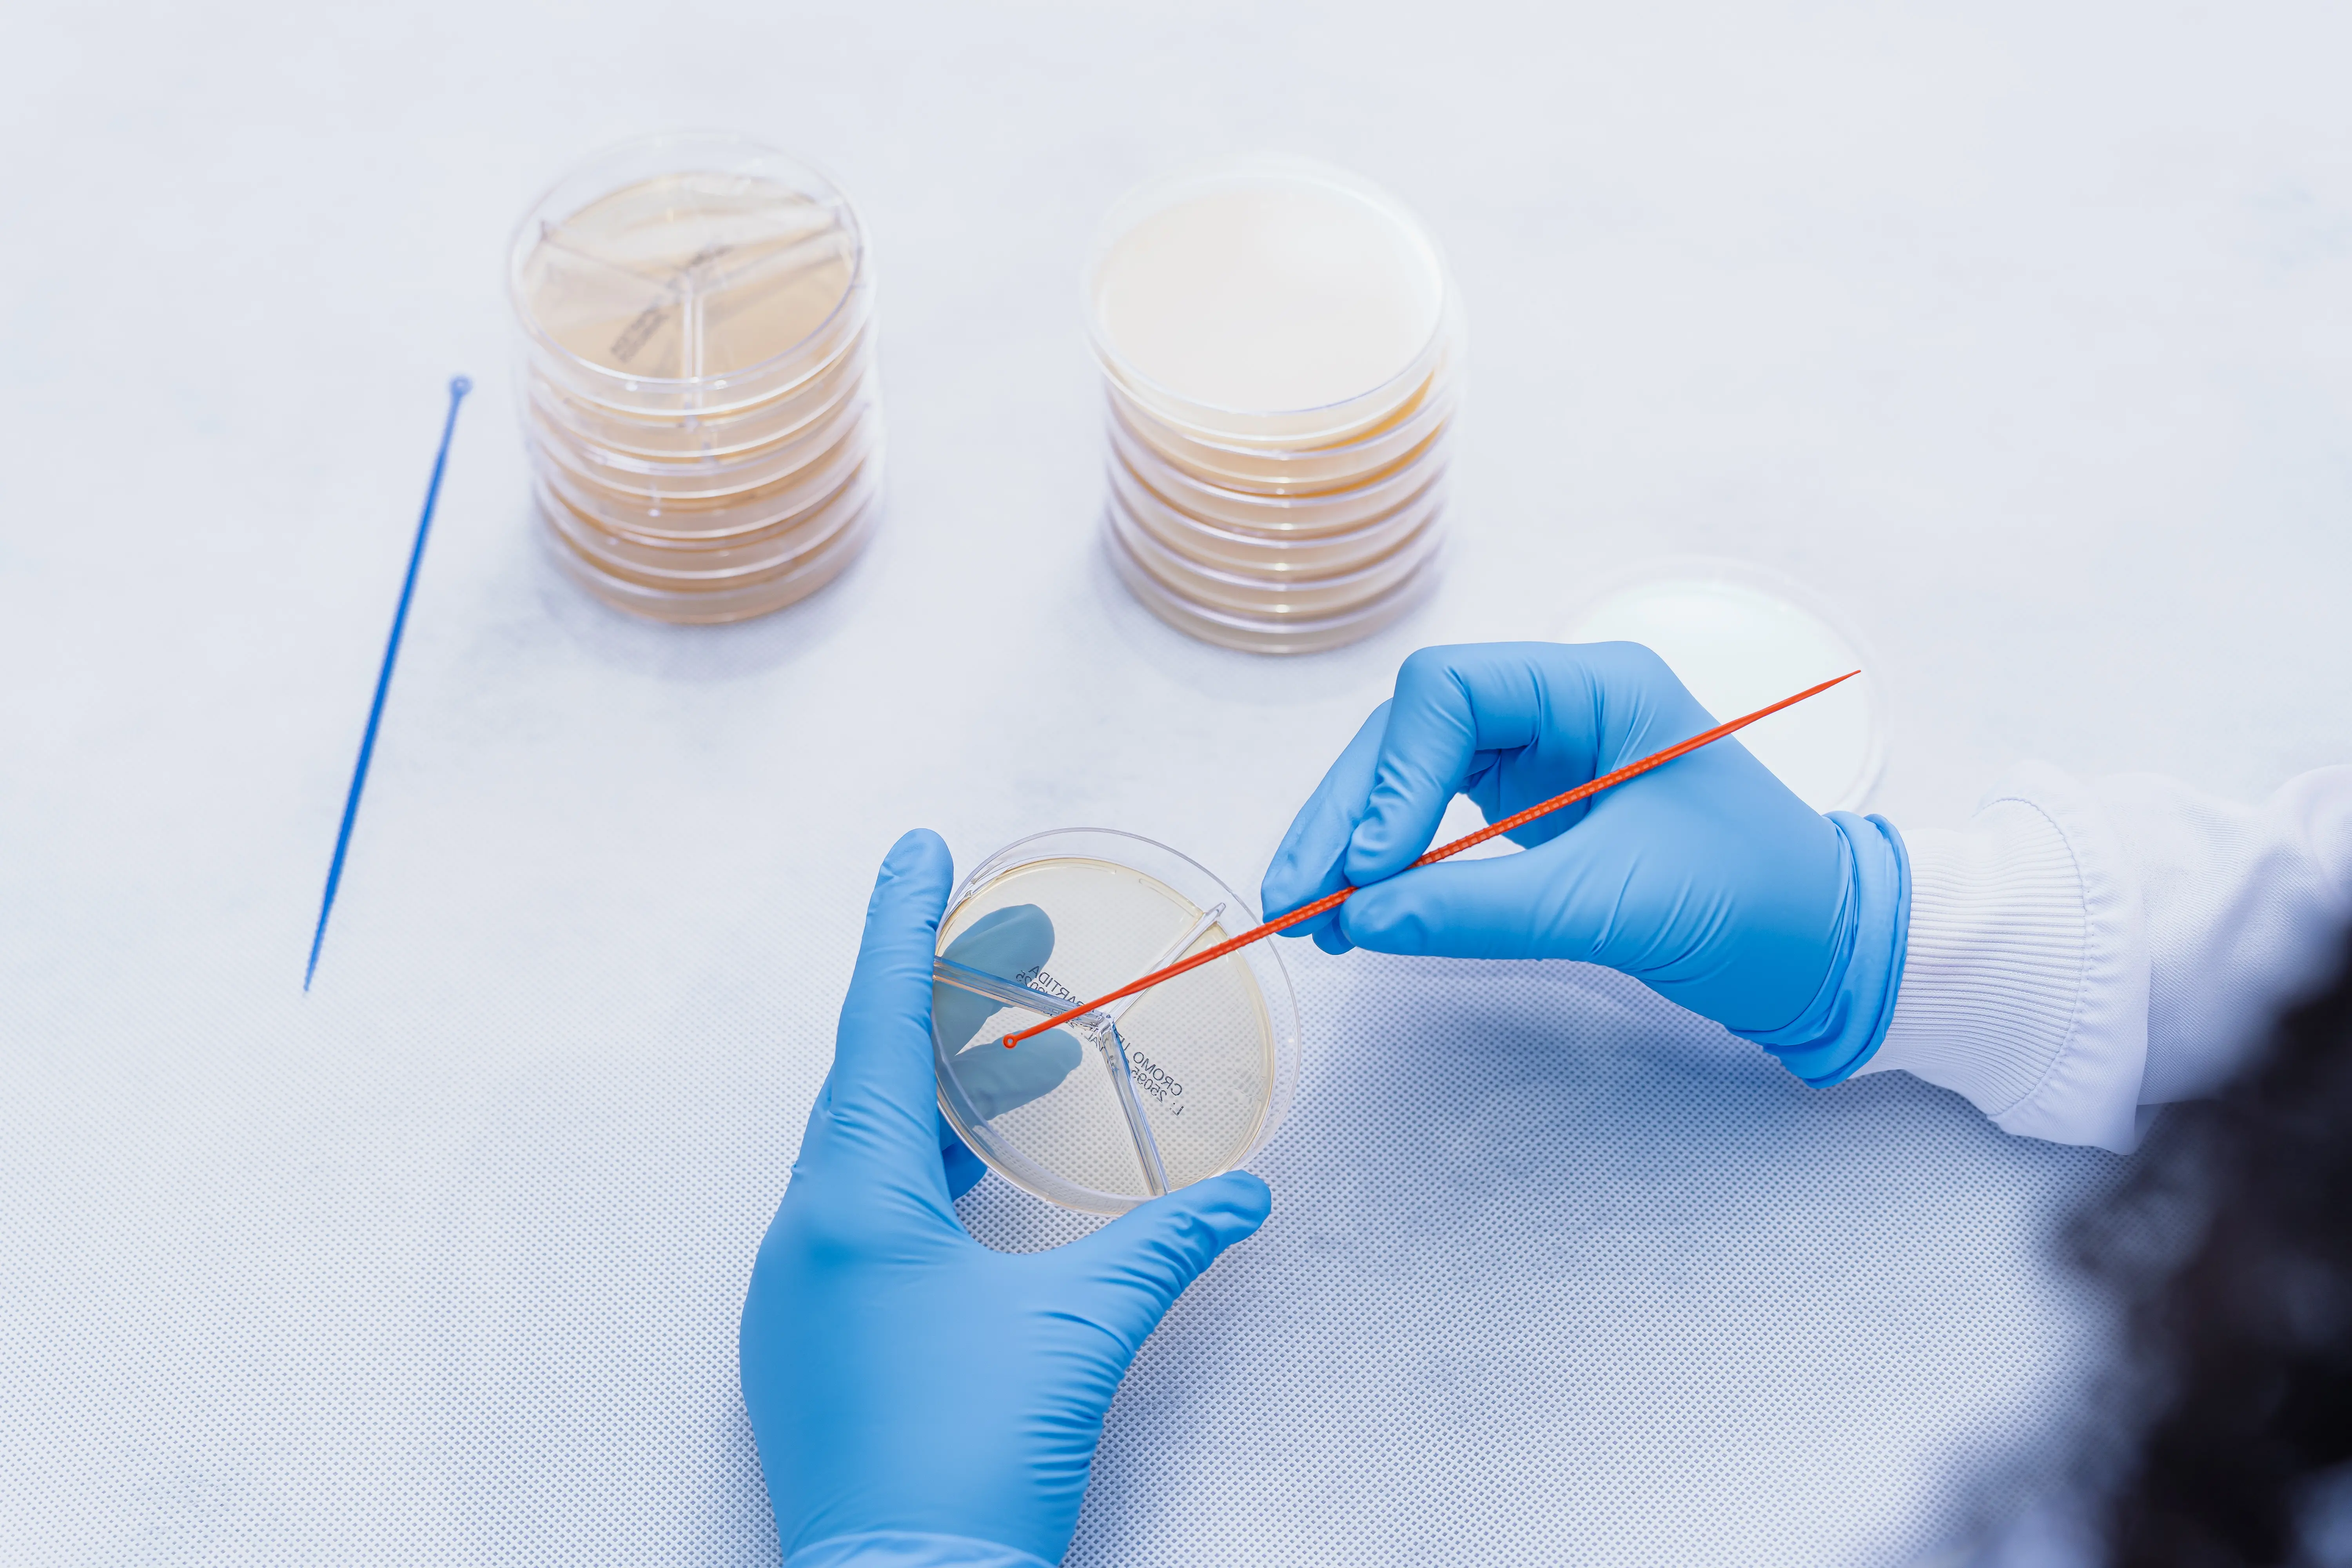
Micro-organismos estão presentes do diagnóstico de doenças à produção de alimentos, medicamentos e insumos essenciais. Em live do MICROmeio com a Kasvi, especialistas discutiram tendências, desafios e oportunidades da microbiologia para 2026.

Ouça este conteúdo
A microbiologia é a área da ciência dedicada ao estudo de organismos microscópicos, como bactérias, vírus, fungos, protozoários e algas, incluindo formas procariontes e eucariontes inferiores. Com aplicações que atravessam a saúde, a indústria, o meio ambiente e a educação, o campo vem se consolidando como um dos mais estratégicos da ciência. Essa diversidade de atuação evidencia a presença dos microrganismos em processos do cotidiano, do diagnóstico de doenças à produção de alimentos, medicamentos e outros insumos necessários para a sociedade.
Para dimensionar o mercado e as oportunidades ligadas à área, o canal MICROmeio, em parceria com a Kasvi, uma empresa brasileira dedicada a oferecer soluções para pesquisa, ciência, diagnósticos, estudos e novas descobertas, realizou a live Campos de Atuação em Microbiologia: Tendências e Oportunidades para 2026 | Kasvi no Micromeio. O encontro discutiu os principais campos de atuação, os desafios e as tendências para os próximos anos e os caminhos possíveis diante das transformações do mercado científico.
Atualmente, a formação em microbiologia permite trabalhar em áreas como clínica, industrial, ambiental, de alimentos e bebidas, molecular e genética, além de pesquisa e docência, saúde pública, epidemiologia, veterinária, controle de qualidade, biossegurança e nos setores farmacêutico e de cosméticos. Esses são apenas alguns dos ramos existentes, que tendem a se expandir conforme avançam os estudos e cresce a demanda por conhecimento científico aplicado às necessidades da sociedade e do mercado.
Durante o encontro, a bióloga e mestre em ciência Nathalia Nascimento, que atua na área comercial da Kasvi, destacou que apesar das possibilidades do campo, a base para os diferentes setores permanece a mesma. “Mesmo com diferentes microrganismos e em diferentes lugares, os testes que fazíamos para identificar acabavam sendo os mesmos, como a placa com meio de cultura e o ELISA. Nos últimos anos, passamos a utilizar o PCR. Então, apesar de eu estar no solo, na água, testando um pão, um queijo ou até mesmo trabalhando numa parte mais genômica, querendo ou não, todas as áreas já passaram por essa parte do plaqueamento e identificação. Basicamente, essas áreas vão trazer a base da microbiologia. E é nisso que surgem os desafios, mas também as oportunidades de inovação”, destacou.
Desafios do campo
Os desafios atuais da área vão desde o aumento da resistência a antibióticos,a emergência de novas cepas patogênicas e a necessidade de diagnósticos rápidos, a mudanças climáticas, regulamentações e transformações nos hábitos de consumo. Segundo Nathalia, a microbiologia necessita acompanhar as mudanças da sociedade. “Da mesma maneira que um novo celular foi lançado e as pessoas conseguem gravar vídeos de 30 segundos explicando a teoria do mundo, a humanidade quer que, ao sair do laboratório, o teste já esteja no aplicativo do celular, ou que o alimento chegue de forma rápida”.
A mudança de hábitos da população implica na forma de fazer produtos, de vender e de inovar. A bióloga deu um exemplo fictício sobre uma fábrica de salgadinhos que, por 20 anos produziu alimentos transgênicos, mas a partir do momento em que a população decidiu não se alimentar mais desta maneira, é necessário ter uma troca. Estar atualizado em relação a tendências e ter um estudo constante das áreas são necessários para inovação e modernização, que apesar de serem desafios, são oportunidades de expansão.
Para contornar os desafios, estão a análise genética, que auxilia na eficiência e combate de doenças, produção de novas vacinas, remédios, produtos e alimentos e as propriedades e utilização das fábricas vivas, que ampliam o estudo não apenas a identificação do microrganismo, mas todas as suas propriedades e possibilidades de utilização.
A modernização nos processos não é algo distante, pois já acontece há algum tempo. Antes, as análises eram feitas em cerca de oito dias, mas hoje é possível ter resultados em poucos minutos. Essa velocidade traz diversos benefícios para todos os campos, principalmente a área industrial, que dentro do mercado financeiro apresenta projeção de crescimento de mais de 8% até 2028, segundo a bióloga. Assim como a ambiental, que cresceu assim como as preocupações políticas e da sociedade em torno do cuidado com o meio ambiente.
Tendências para 2026
Especialistas indicam uma microbiologia cada vez mais integrada entre seus diferentes campos de atuação. Embora lidem com microrganismos e contextos distintos, essas áreas compartilham uma base comum, o que reforça a importância da conexão entre métodos e aplicações. Nesse cenário, a inovação está menos ligada à substituição das técnicas tradicionais e mais ao aprimoramento, à combinação de métodos já consolidados e à incorporação de novos processos.
Quando um campo consegue desenvolver análises que utilizam menos tempo e recursos, mas entregam resultados mais completos, rápidos e eficazes, os ganhos se estendem a toda a cadeia. O avanço no entendimento dos microrganismos, com maior precisão e agilidade, permite decisões mais assertivas, redução de custos e aumento da eficiência em diferentes setores.
Esse movimento também reflete diretamente no mercado de trabalho, com a ampliação da demanda por profissionais qualificados, atualizados e capazes de atuar de forma transversal entre diferentes áreas da microbiologia. Para Marcus Vinícius, do MICROmeio, estagiar é uma das partes mais importantes para entrar no mercado da microbiologia. “Se você tem tendência, procure. Não interessa se você acabou a faculdade ou você está no meio da faculdade, vá pro estágio”. A tendência é a valorização de perfis que dominem a base técnica da área, aliada ao uso de novas ferramentas e processos, acompanhando a modernização do setor e as exigências de um mercado cada vez mais integrado e dinâmico.




